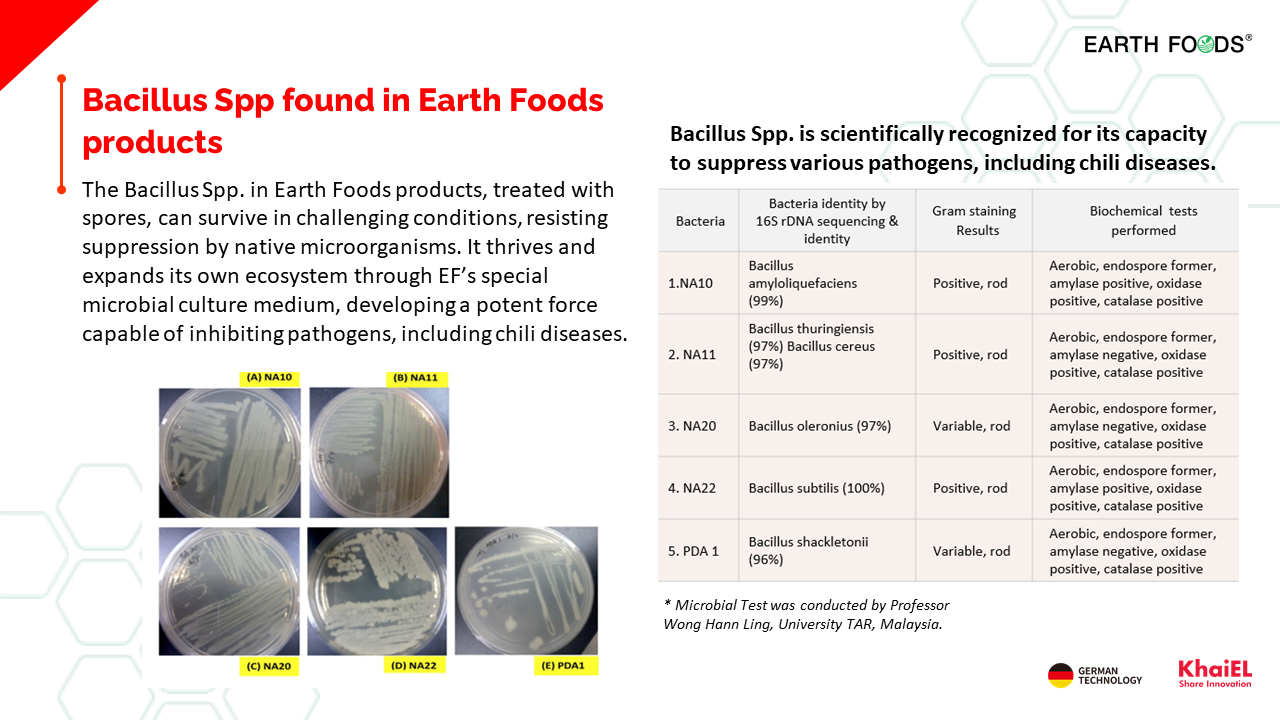

Dual-Tier Irrigation System
(DTI)
Dual-Tier Irrigation System (DTI) is Earth Foods' Solution to restore chili peppers to their normal lifespan.
-
Features: Fully organic cultivation method for greenhouses.
-
Nutrient solution: Uses EF formula organic liquid, replacing traditional fertilizers (AB fertilizers that require mixing and dilution before use).
-
Strong leaves and roots: A reinforced formula specifically designed for the growth of leaves and roots.
-
High-nutrition crops: Produces crops with full nutrition, which are not only more nutritious but also exceptionally delicious.
-
Low pesticide usage: No need to apply bacterial pesticides.
-
Extended growing period: Plants are strong and healthy, with prolonged lifespan and fruiting period due to the absence of disease interference.
This system is not only suitable for growing chili peppers but also for any plants that can be grown in cultivation packs, such as tomatoes, flowers, strawberries, and more.